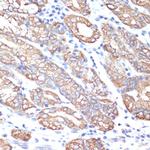
Cytokeratin 18 Antibody in Immunohistochemistry (Paraffin) (IHC (P))

Search
Invitrogen
Cytokeratin 18 Polyclonal Antibody
{{$productOrderCtrl.translations['antibody.pdp.commerceCard.promotion.promotions']}}
{{$productOrderCtrl.translations['antibody.pdp.commerceCard.promotion.viewpromo']}}
{{$productOrderCtrl.translations['antibody.pdp.commerceCard.promotion.promocode']}}: {{promo.promoCode}} {{promo.promoTitle}} {{promo.promoDescription}}. {{$productOrderCtrl.translations['antibody.pdp.commerceCard.promotion.learnmore']}}

Please note: We are reviewing Western blot images included in the antibody testing data in our catalog, including those provided by third parties. Unless expressly labeled or annotated as “raw-unedited”, Western blot images included in the antibody testing data in our catalog may have been edited, optimized or otherwise adjusted for presentation.
产品信息
PA5-120073
种属反应
宿主/亚型
分类
类型
抗原
偶联物
形式
浓度
规格
纯化类型
保存液
内含物
保存条件
运输条件
RRID
产品详细信息
Positive test controls include: HeLa, HT-29, HepG2, K-562,Mouse liver, Mouse kidney. The target is usually found in the following locations: Cytoplasm, Nucleus, nucleolus, perinuclear region.
Immunogen sequence: SHYFKIIEDL RAQIFANTVD NARIVLQIDN ARLAADDFRV KYETELAMRQ SVENDIHGLR KVIDDTNITR LQLETEIEAL KEELLFMKKN HEEEVKGLQA QIASSGLTVE VDAPKSQDLA KIMADIRAQY DELARKNREE LDKYWSQQIE ESTTVVTTQS AEVGAAETTL TELRRTVQSL EIDLDSMRNL KASLENSLRE VEARYALQME QLNGILLHLE SELAQTRAEG QRQAQEYEAL LNIKVKLEAE IATYRRLLED GEDFNLGDAL DSSNSMQTIQ KTTTRRIVDG KVVSETNDTK VLRH
靶标信息
Cytokeratin 18 (Keratin 18, KRT18, type I cytoskeletal 18) belongs to the type A (acidic) subfamily of low molecular weight keratins, exists in combination with cytokeratin 8. Tissues from gastrointestinal tract, respiratory tract and urogenital tract, as well as endocrine and exocrine tissues and mesothelial cells are positive for cytokeratin 18. Further, cytokeratin 18 is found primarily in non-squamous epithelia and is present in a majority of adenocarcinomas and ductal carcinomas, but not in squamous cell carcinomas. Hepatocellular carcinomas express only cytokeratins 8 and 18. Mutations in the cytokeratin 18 gene have been linked to cryptogenic cirrhosis. Two transcript variants encoding the same protein have been found for the cytokeratin 18 gene. Cytokeratin subtype expression patterns are used to an increasing extent in the distinction of different types of epithelial malignancies. The cytokeratin antibodies are not only of assistance in the differential diagnosis of tumors using immunohistochemistry on tissue sections, but are also a useful tool in cytopathology and flow cytometric assays.
仅用于科研。不用于诊断过程。未经明确授权不得转售。
篇参考文献 (0)
生物信息学
蛋白别名: Cell proliferation-inducing gene 46 protein; CK 18; CK-18; Cytokeratin endo B; Cytokeratin-18; Cytokeratin18; Endo B; K 18; K18; keratin complex 1, acidic, gene 18; Keratin D; Keratin, type I cytoskeletal 18; Keratin-18; Keratin18; KRT 18; krt18 {ECO:0000250|UniProtKB:P05783}; type I cytoskeletal 18
基因别名: CK18; CYK18; K18; Kerd; Krt1-18; KRT18; PIG46
UniProt ID: (Rat) Q5BJY9, (Mouse) P05784
Entrez Gene ID: (Rat) 294853, (Mouse) 16668




